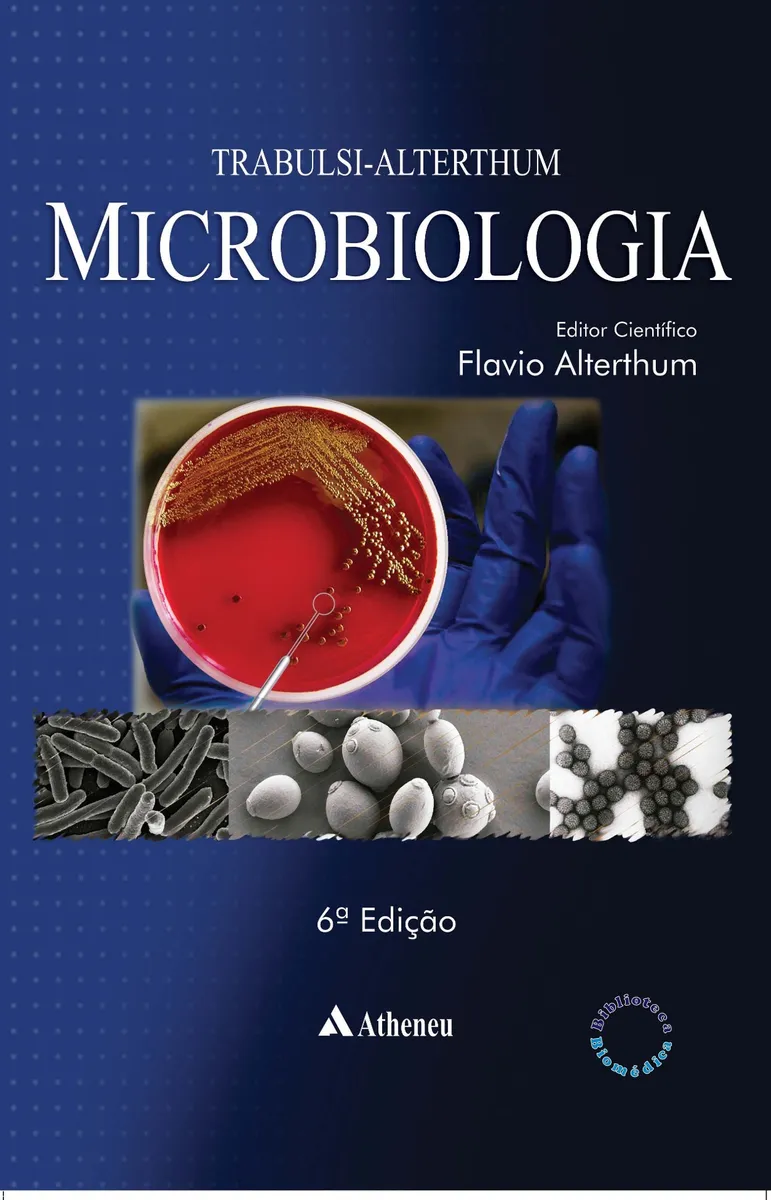

Loja da Biochemie
Loja da Biochemie
As melhores indicações para Cientistas
A Loja da Biochemie reúne indicações de produtos pensados para apoiar, de forma prática, a rotina de estudos, trabalho e desenvolvimento profissional.
As compras são feitas diretamente pelo site ou aplicativo do Mercado Livre, o que garante um processo seguro, com diferentes opções de pagamento e entrega.
A Biochemie atua apenas na curadoria e recomendação dos itens. Todo o processo de pagamento, envio, garantia e entrega fica sob responsabilidade do próprio Mercado Livre.



Livros para Cientistas
Seleção de livros técnicos e científicos para aprofundamento profissional.


Schrödinger e Heisenberg: Física Além do Senso Comum (2008), de Antonio Fernando Ribeiro de Toledo Piza.

Biotecnologia Industrial: Biotecnologia na Produção de Alimentos (2021), de Iracema de Oliveira Moraes.
Livros para Aperfeiçoar a Carreira Profissional
Livros voltados para desenvolvimento profissional, carreira, liderança, comunicação e posicionamento estratégico no mercado.



Inteligência Artificial na Educação: Guia Prático para Professores Inovadores, de Ezequiel R. Zorzal.

Storytelling: Aprenda a Contar Histórias com Steve Jobs, Papa Francisco, Churchill e Outras Lendas da Liderança (2019), de Carmine Gallo.


Comunicação Não Violenta: Técnicas para Aprimorar Relacionamentos Pessoais e Profissionais, de Marshall B. Rosenberg.

Tablets para Estudos e Trabalho
Dispositivos ideais para leitura de artigos, organização de estudos, anotações e produtividade no dia a dia.






Notebooks para Estudos e Trabalho
Equipamentos recomendados para atividades acadêmicas, laboratoriais e profissionais, com foco em desempenho e confiabilidade.














Celulares
Smartphones selecionados para produtividade, comunicação e uso profissional no dia a dia.tos recomendados para atividades acadêmicas, laboratoriais e profissionais, com foco em desempenho e confiabilidade.













